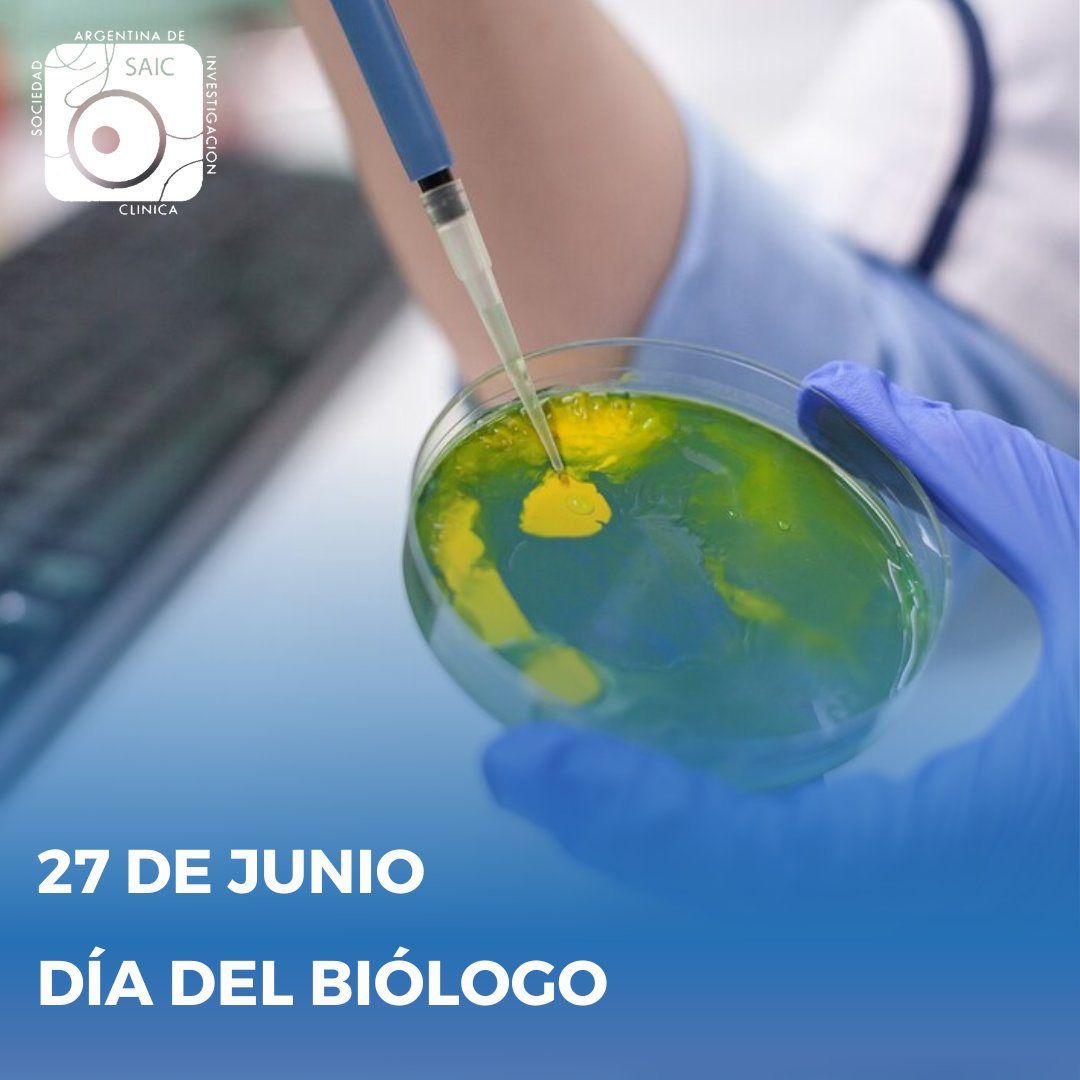
Día del biólogo

En 1812, el Triunvirato llevó a cabo el primer acto oficial vinculado a esta profesión en la Argentina al crear el Museo de Historia Natural. Cada 27 de junio se celebra el día que resalta la conservación de la naturaleza.

#diadelbiologo
#27dejunio

SAIC oficial
@saicoficial
Sociedad Argentina de Investigación Clínica
ID: 2554263107
http://www.saic.org.ar 19-05-2014 16:55:37
517 Tweet
247 Followers
41 Following




Convocatoria para el Premio Fima Leloir 2025 Hasta el 9 de junio podrán postularse quienes se dediquen a la investigación básica en Ciencias Biomédicas, Biología o Fisiología. Consultas e información: [email protected] #premio #notequedesafuera



LAMP para diagnóstico molecular. 📆Fecha: 10 al 29 de junio 2025 🚶♀️Modalidad: virtual 💸Arancel: $32.000 (EXCLUSIVO SOCIOS SAIC) [email protected] #diagnosticomolecular #LAMP





REUNIÓN CIENTÍFICA CONJUNTA DE LA SAIC Y LA SAH. “Medicina de precisión: un puente entre la Clínica y el Laboratorio Molecular” ⏰ Horario: 13hs. 🗓️ Día: 4 de julio 🚌 Modalidad: Hibrida Inscripción: SAIC: [email protected] SAH: [email protected] #reunionconjunta #medicina




¡Recibimos en el marco del programa CIENCIA 2025 de la Fundación Williams un subsidio para la organización de nuestra reunión anual 2025! Agradecemos infinitamente a la Fundación Williams por seguir confiando en SAIC. Fundación Williams #ReunionesCientificas2025 #FundacionWilliams





Curso de Posgrado en Biofármacos 2025 7 de agosto al 13 de noviembre 2025 Clases teóricas, espacio de trabajos prácticos grupales. Inscripciones hasta el 4 de agosto. Proceso de selección. ¡Cupos limitados! [email protected]